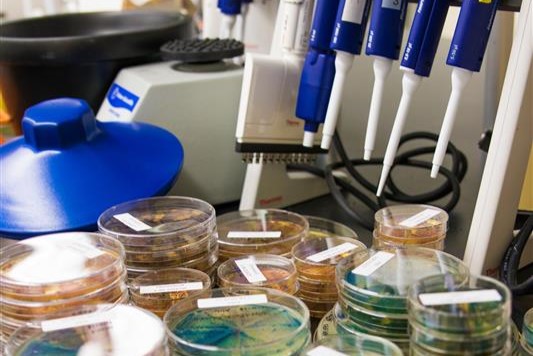
BioSci

Weekend Schedule
Signature Events

Homecoming Street Festival
3-6 p.m. | Saturday, Feb. 28, 2026
Location: Mesa Road
Enjoy live performances, family-friendly activities, delicious food, carnival games and the energy of the pep rally and fireworks. This is your moment to celebrate what it means to be an Anteater!

Men’s Basketball Game
7:30 p.m. | Saturday, Feb. 28, 2026
Location: Bren Events Center
Experience the thrill of Homecoming on the court! Cheer on the Anteaters in their highly anticipated, ESPN2-televised matchup against UC Santa Barbara at the Bren Events Center.
A limited number of discounted tickets are available for UC Irvine alumni purchase. Alumni status will be verified. Also, while supplies last, UC Irvine alumni can purchase a special edition Peter the Anteater bobblehead during checkout. Please note, that bobbleheads are only available to basketball attendees. Secure your one-of-a-kind collectible before it’s too late!
More Homecoming Events
Friday, Feb. 27, 2026

ANTrepreneur Center Open House
1-3 p.m. | Friday, Feb. 27, 2026
Location: ANTrepreneur Center, 233 Pereira Dr., Irvine, CA, 92697
Discover the creative energy at UC Irvine’s ANTrepreneur Center! Swing by our open house to explore innovation in action. From our podcast studio and mini maker space to our student-run repair center. Meet the team, connect with student founders, and see how we help ideas come to life through hands-on workshops, 1:1 coaching, and paid micro-internships. Whether you’re curious, creative or just want to check out something cool, come be inspired!
Charlie Dunlop School of Biological Sciences Lab Tour
2:30-4 p.m. | Friday, Feb. 27, 2026
Location: Charlie Dunlop School of Biological Sciences, Meet in the lobby of BioSci 3
Dr. Witbracht will discuss Alzheimer’s disease and healthy brain aging including the history, biology, prevalence, risk factors and risk reducing behaviors.

Merage Alumni Weekend: Insights Summit
4-8 p.m. | Friday, Feb. 27, 2026
Location: Paul Merage School of Business, 4293 Pereira Dr, Irvine, CA 92697
The Insights Summit kicks off the Merage Homecoming Weekend with a day dedicated to professional development and thought leadership. Alumni and industry leaders will share cutting-edge insights across various business disciplines, fostering knowledge exchange between seasoned professionals and emerging talent.
Additional details on Breakout Sessions will be shared closer to the event.

Men’s Volleyball vs. UCLA
Saturday, Feb. 28, 2026

Community Brunch at the Cross-Cultural Center
12 p.m.-3 p.m. | Saturday, Feb. 28, 2026
Location: Cross-Cultural Center Main Lobby
Kick off Homecoming Weekend by celebrating the heart of our campus community! Join us at the Cross-Cultural Center for a special brunch honoring the alumni who champion our mission and the students who bring our center to life every day.
Since October 16, 1974, the CCC has been UC Irvine’s original multicultural center – the first of its kind in the UC system – providing vital social-cultural support for our diverse student community. Founded by dedicated faculty, staff, and students who recognized the need for a space where everyone belongs, the CCC continues to be a home away from home for generations of Anteaters.
This brunch is the perfect pre-party and tailgate before heading to the Bloc Party, so come ready to mingle, reminisce and show your Anteater pride!

ICS Lunch
12 p.m.-1 p.m., check-in begins at 11:30 a.m. | Saturday, Feb. 28, 2026
Location: Newkirk Alumni Center Den, 450 Alumni Court, Irvine, CA 92697
Join fellow ICS alumni and faculty for a luncheon before The Future is Now: Discovering the Power of AI lecture.
Please note: This event is only open to invited guests. An access code is required for registration.

Young Alumni Anteater Meetup
1-2:30 p.m. | Saturday, Feb. 28, 2026
Location: Eureka!
Tickets: $15
Start your Homecoming celebration with the UC Irvine Young Alumni Council at a special Homecoming Kickoff designed just for young alumni. Before heading to the Homecoming Block Party, gather with fellow Anteaters for an exclusive pre-event, featuring great food, refreshing drinks and a chance to reconnect and build community. This is the perfect way to ease into the afternoon, celebrate your UC Irvine pride, and make the most of Homecoming.
Tickets Include food, drinks and a collectible UC Irvine glass to keep as a Homecoming memento.
After the kickoff, guests are encouraged to walk together to the Homecoming Block Party, which begins at 3 p.m., continuing the celebration with the broader Anteater community.

ICS & Reunions: The Power of AI
1:30-2:30 p.m., check-in begins at 1 p.m. | Saturday, Feb. 28, 2026
Location: Newkirk Alumni Center Conference Room, 450 Alumni Court, Irvine, CA 92697
The future isn’t coming – it’s already here. Join fellow Anteaters at this exclusive event for qualifying alumni for an exciting look at how artificial intelligence is reshaping our world in real time. Explore how this rapidly evolving technology is transforming the way we live and imagine what’s next as we step boldly into the age of AI.
Please note: This event is only open to invited guests. An access code is required for registration.

Class Celebrations & Golden Anteaters: Kicking Off Homecoming Together!
2:30-5 p.m. | Saturday, Feb. 28, 2026
Location: Newkirk Alumni Center, 450 Alumni Court, Irvine, CA 92697
It’s time to celebrate if your class year ends in 1 or 6 (example: 1986) or you’re a Golden Anteater with class years from 1966 to 1976!
A special gathering is planned just for you to start off the Homecoming festivities and celebrate your class milestone. Start with an exclusive AI Lecture, then enjoy a private celebration with fellow Anteaters. Bring fellow classmates, enjoy refreshments and raise a glass to your milestone. The first 100 milestone alumni (from each class) will receive a special UC Irvine keepsake to commemorate the occasion.
This kickoff event takes place right next to the festival – giving you easy access to parking and a short walk to Homecoming.
Limited space, order now!
Please note: This event is only open to invited guests. An access code is required for registration for this event and the AI Lecture.
Sunday, March 1, 2026

Merage Alumni Weekend: Disney Day Meetup
10 a.m. | Sunday, March 1, 2026
Location: Disneyland Resort, Sleeping Beauty Castle
Conclude the Merage Homecoming Weekend with a magical day at the Happiest Place on Earth! This casual, family-friendly gathering allows alumni to bring their families and enjoy Disneyland together. We’ll meet for a group photo at the iconic Sleeping Beauty Castle, then everyone is free to explore the park at their own pace.
This is a wonderful opportunity for:
- Alumni with families to connect in a relaxed setting
- Multi-generational Anteater bonding
- Creating lasting memories with the Merage community
All guests must purchase their own park tickets, parking and add-ons directly through the Disneyland Resort website. A valid theme park reservation is required at the Disneyland Resort. To purchase park tickets and add-ons, visit their website.
What to Expect
- 10 a.m. group photo at Sleeping Beauty Castle
- Optional informal meetups throughout the day
- Shared Disney tips and recommendations from fellow alumni
- Flexibility to enjoy the park with your group

UC Irvine Spirit Night with the Anaheim Ducks
5 p.m. | Sunday, March 1, 2026
Location: Honda Center
Join the Anteater community at UC Irvine Spirit Night with the Anaheim Ducks on Sunday, March 1 at 5 p.m. Celebrate UC Irvine’s 60th Anniversary and enjoy an evening of exciting hockey as the Ducks take on the Calgary Flames. Discounted tickets for UC Irvine alumni are available for purchase here. As part of this special event, attendees will receive a limited-edition Ducks/UC Irvine 60th Anniversary sweatshirt. Come out and show your Anteater pride while cheering on the Ducks!